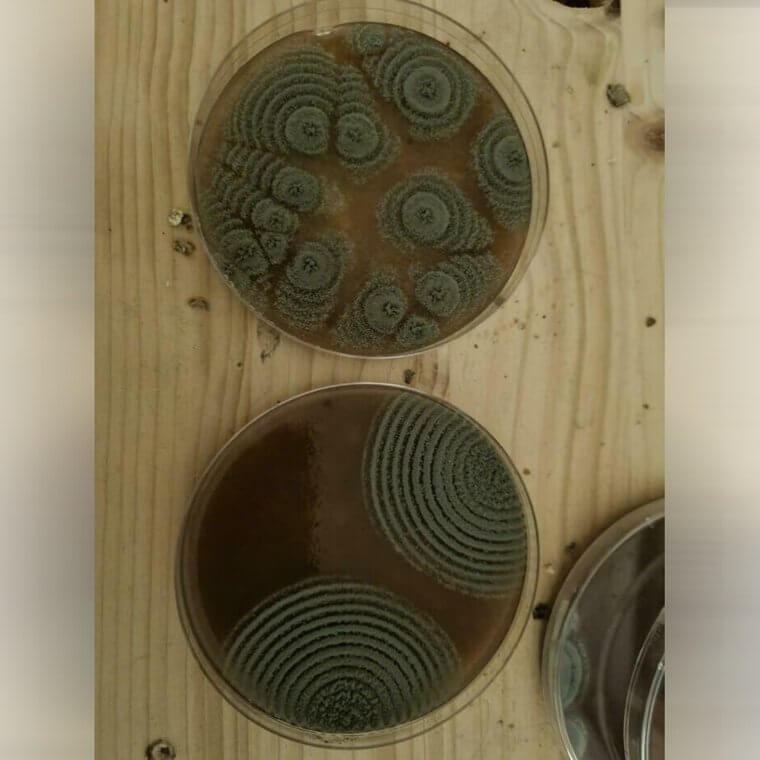
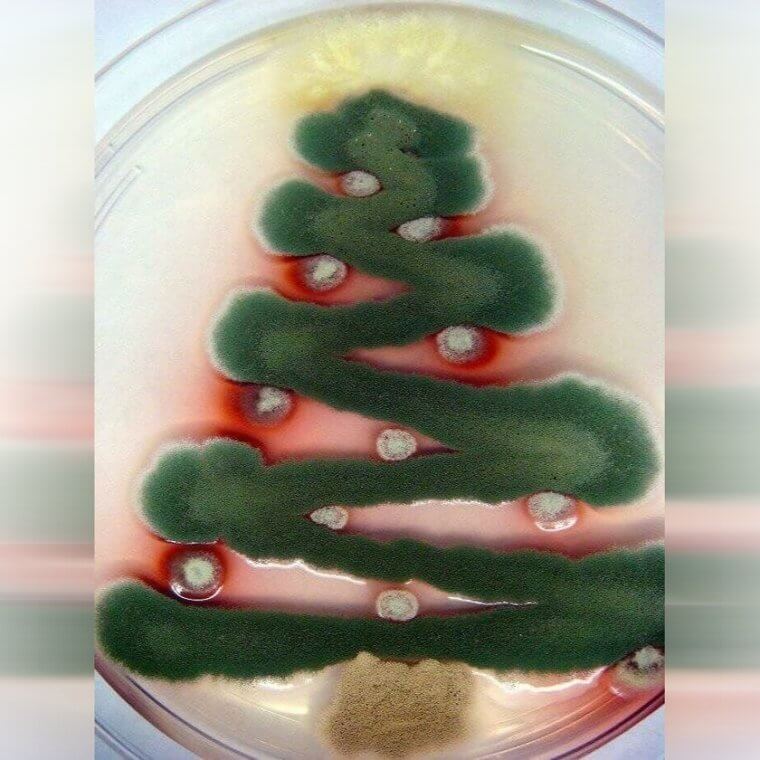
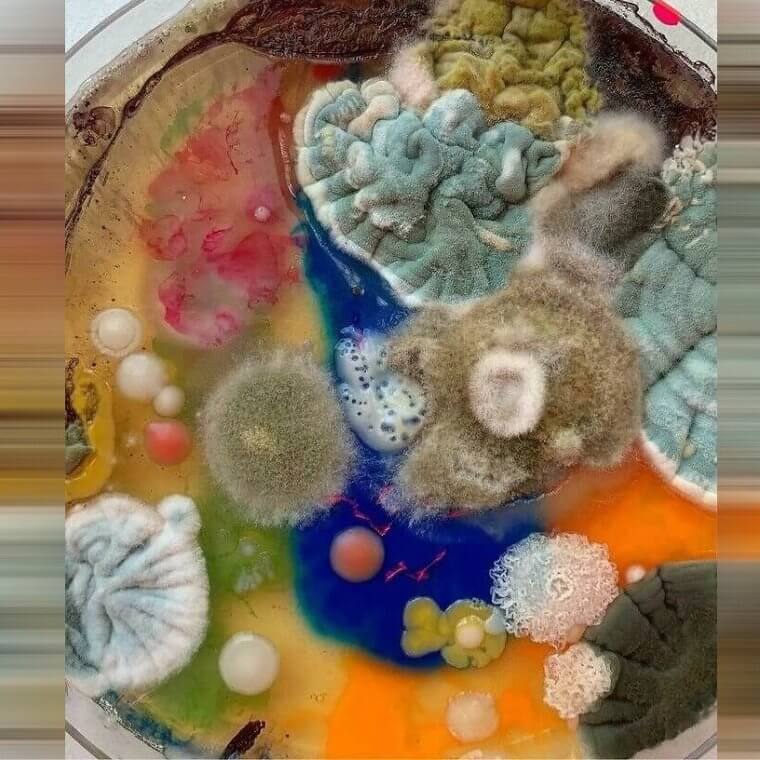

Moldy Cream Cheese Created an Empire
Have you ever seen mold create almost an entire city like creation on the top of a piece of food? Well, that is exactly what this mold did and it definitely made a one of a kind creation. Just look at the structures and the shapes and the colors. All that it needed to create this was some cream cheese and time. After some waiting they revealed the end result.
It is interesting how there were so many different colors and types of mold on one piece of cream cheese. They probably never wanted to eat cream cheese again after seeing this.
A Colorful Rainbow of Mold
This is probably not the first picture that would come to your mind when you imagine mold. The most colorful version that you're used to is probably the greenish blue that forms on the top of food. However, as can be seen, there are many, many more colors that can be formed when mold is left to grow uninhibited. Just look at this rainbow of moldy colors and try not to be impressed.
This almost looks like it could be a painting that would be sold at art exhibits. It's quite an impressive sight and to think that it's natural and it's just mold.
Fuzzy Mold Overtook the Pumpkin
Did you ever think that maybe mold has a sense of humor? Well, this picture might just convince you that it does. After all, it could have chosen to grow all over this cut up pumpkin that was left abandoned after Halloween, but it chose to grow specifically in the areas that would make the pumpkin look like an old man. That is some exceptional mold growth.
It almost looks as if the people who had this pumpkin outside of their house knew this would happen and were just waiting for the moment of fuzz to arrive.
A Piece of Mold or a Baby Seal?
Did you ever think you would look at a piece of mold and think to yourself "oh, this is actually quite cute"? The answer to that is probably no, and yet somehow this piece of mold managed to do the impossible. It is almost as if it was trying to impersonate a seal, an animal that most people love and find adorable. And it is doing a good job at the impersonation.
It really looks like a seal because it is swimming in a pool of milk (or some other similar substance) just as seals swim in the cold water.
When Your Agar Plate Turns Into Moldy Art
You probably never thought that an agar plate could turn into a piece of art. After all, they are usually used to cultivate microorganisms. That isn't usually a pretty or artistic task. However, this mold had different plans and was ready to show the world just how beautiful mold could be. It turned itself into pretty green little pieces of art that are fit to hang on any person's wall.
These really look like modern art in particular. They could easily pass as some prints that are hung up in bedrooms or living rooms. If someone tried to sell them online they would likely be successful.
This Mold Is Ready for Christmas
It looks humans are not the only organism that gets excited for the holidays. This mold could have chosen any form to turn into, but it "chose" to become a Christmas tree. There's no way this was not intentional and was not intended to be a piece of art. It even has a little star at the top of the tree and countless red and silver Christmas tree ornaments.
This is the type of gift that you should give to the nerdy friend for the holidays. Even if you just use it as a holidays greeting card.
Cat Food With a Moldy Mohawk
If you were ever looking for a sign that you shouldn't risk leaving food out for too long, here it is. Although that left out food might create a pretty cool piece of art like mold, that's probably not what you want on your hands. However, if you're looking for a cool science experiment this is a good one. You can compare results of all the different mold creations at the end.
If you look closely or even just briefly, it almost looks like this is the top of a person's head. The mold has created a mohawk for the container of cat food.
Is This a Dog or a Moldy Pot?
It can be surprising to see how quickly mold can grow and reproduce and esentially take over. After all, this person was out sick with pneumonia for only about a week. When they were well enough to get up and clean the house, they were shocked to see this. How did this grow in such a short period of time? It was hard to believe that it wasn't just his cat resting in the bowl of food.
At that point the person should just dispose of the pot. There is no way they can get rid of that mold infestation and especially not easily.
From a Swab of the Bottom of a Shoe to This Masterpiece
Science is such a fun thing... If you're interested in seeing how a small swab taken from the bottom of a person's shoe can turn into this masterpiece. Or maybe science isn't even that cool and just mold is. After all, who would have thought that one small swab could turn into such an elaborate and colorful piece when it was just let to soak and rest for a bit?
If you look quickly, it almost seems like this is a bowl of food, a yummy soup. It's hard to understand that it's actually just mold growths.
When Mold Takes Over the Ceiling Fan
If you ever wanted to understand the strength of mold and just how intense it could get, then this is the photo for you. It's hard to imagine how long it took for this ceiling fan to be overtaken with mold, and where the moisture was coming from that allowed it, but there is no I seeing this once you gaze upon it. It's both beautiful and horrifying.
This literally looks like something directly out of a horror film. If you walk into a haunted house and see this, just run. The state of your health is worth it.
When Mold Takes Over
There is nothing worse than accidentally leaving food in the fridge for a long time and then coming back to realize it when it is too late. It was far too late for this person and they reached the point of no return. They shouldn't even open that container or try to clean it. It is too much of a health hazard at that point and should just be thrown away.
They think that it was oroginally mashed potatoes, but there is no way to tell or for them to know what it actually was. Too much time has passed and the mold took over.
The Moldy Pineapple Is Watching You
Did you know that sometimes mold can grow eyes and watch you? Well, not in the literal sense, but it can happen in the appearance sense, just like this. This person's pineapple grew little eyes and appeared to be staring at them from the plate. If you don't like mold, this could be a very scary moment for you. After all, most people dont like to be stared at, especially not by mold.
No one should be eating those pieces of pineapple and it's a little disturbing that they are in someone's lunchbox as if they're completely edible.
The Mold Is Networking
Maybe all the conspiracy theorists have it all wrong in thinking that different groups rule the world. Maybe it is just mold that rules the world. After all, look at all this networking that the mold is doing. They could easily expand and grow into a formidable force just from this. And if this doesn't look enough like the beginning of a sci-fi movie to you, then who knows what is.
At the same time, this also looks like a hunch of stars that are interconnected in the brown universe that is just coffee.
Is the Gourd Painted or Is It Mold?
Genuinely, look at this beautiful orange gourd. Appreciate it's decorative beauty. And then look at the designs that are all over it in black. Do you think that those designs are painted on or are they mold? Although most people would probably think that they are painted in, they are indeed just mold. Mold that decided to be incredibly and impressively aritistic in ways that most humans could probably never imagine.
People need to take notes on these designs. They genuinely look like the handiwork of a talented artist, not the reckless creation from mold.
The Watermelon Juice Was Invaded by Mold
It's funny to think that something like watermelon juice would become moldy. Of course, one of the easiest and simplest things to grow is mold, but it seems strange that it could grow in just plain juice. What is even stranger is how is grew in this watermelon juice. It grew in balls that formed seperatley in the juice. It almost looks like Boba tea in a way.
It might be hard for some people to even realize that this is not how the juice is supposed to look and that they balls are not an addition.
Moldy Marmalade Makes a Kitten
What does moldy marmalade make? Your answer would probably not be a kitten and yet somehow that is exactly what the mold and the marmalade made together. The mold grew on top of the marmalade and it crated this adorable little shake that looks exactly like a kitten. Who would have thought that mold could look so cute. From the little seal to the kitten, what other animals will it impersonate?
Even the colors of this one are cute. You have the orange of the marmalade in the background and then you have the green of the mold. You even have a little black on there for the eyes and whiskers.
When You Don't Know if It's Mold or a Hedgehog
Everyone loves hedgehogs. They cute and friendly and pretty much harmless. However, most people also probably don't want to have a hedgehog in their house without warning. But even that would be better than thinking it is a hedgehog but then finding out that it is actually a bowl of black pin mold that that has spawned out of control over the top of a wet bowl of cat food.
You have to appreciate the art and the creativity of the mold here, but you also would probably be sure to never leave moist food out again.
A Sunflower on a Moldy English Muffin
For whatever reason English muffins are infamous for getting moldy very quickly. They're such a tasty treat and a wonderful thing to have for breakfast that it's hard to give them up, but after seeing what can happen like this, you might be tempted to. Although the mold formed a beautiful sunflower on the English muffin, it is still A LOT of mold. It would be hard to enjoy an English muffin after that.
Although you may no longer enjoy English muffins after this moment, you can still enjoy the beautiful artwork that the mold created on its pallete... The English muffin.
Breaking the Mould of Mold
You probably never thought that mold could be this colorful. After all, when you think of mold you probably think of this in this order: the color green, black mold, and then blue cheese. You probably don't usually think of orange mold or bright cobalt blue mold. But it looks like mold is breaking the mould in this case and going wild with all of the colors of the rainbow.
Which color of this moldy masterpiece is your favorite? They are all unique and bright, but maybe the combination is the best part of this.
When the Mold Grows Like Cauliflower
If you were left out in the wild and you were starving and came across this, you might be surprised by what you thought it was versus what is actually is. While this unarguably looks like cauliflower, this is actually mold. Who knew that mold could impersonate so many things and convince the world that it is something else entirely? This mold was growing under someone's deck and they were shocked when they found it.
Although the shape is already surprising enough, the color of this mold is also fairly alarming. After all, you don't see bright yellow mold every day.
Slime Mold Takes Over a Branch
If you're learned anything from this article, it is probably that there are ENDLESS types of mold and that they come in all different shapes, sizes, and colors. This mold is one that you probably never would have pinned as mold. Hopefully, you can also enjoy the pun there because this slime mold actually looks like a bunch of pins that were placed in the branch and are now jutting out.
The best part of this is that the little bug seems to be enjoying the snack of this funny looking mold. It looks cool and it serves as a nice little treat for bugs. Maybe not all molds are so harmful.
Mold Coming Out of the Ceiling
Having a house that is infested with mold is probably one of the worst things to realize. After all, it is very hard to clean mold without destroying and rebuilding areas completely. And that can be a pretty expensive endeavor. If you are the person who owns this house then you are probably doomed to spend a fortune cleaning out this room. They literally have mold coming out of the ceiling.
Even though this looks bad from this side of the picture and the ceiling, the other side of those panels has to be a pretty terrifying sight to behold.
A Panel of Mold Art
Once again you are presented with some of the most beautiful pieces of art that mold happened to make. Mankind will probably never know if mold knows that it is one of the most artistic things or if it is all by accident and nature is just remarkable. However, this person, who works at a plant tissue culture lab, is constantly surprised by the results that the mold creates.
These look simultaneously like they could be dried flowers while also they could look like watercolor paintings that are used to create pretty color combinations.
A Lid of Black Mold
What happens when you leave a pot full of rice in the back of your cupboard for too long? Well, you probably don't even want to find out or experience it in real life. This person left their freshly cooked rice in the back of the cupboard for just a few days and then they were shocked by the end results. The entire top of the container became covered in black mold.
It was scary and surprising as well how quickly this mold developed on a little bit of rice. If you ever needed a sign to not leave food out for a few days, this is it.
A Cute Little Monster of Mold
Well who would have thought that the words: mold, cute, and monster would ever successfully be used in the same sentence, without the addition of a negative? Probably no one, but this person changed all of that when they found this moldy surface, that had a little monster shaped creature popping out from the top of it and felt the need to draw a face on it just to make it cuter.
You have to give this person points for creativity on this one. Where most people saw a piece of mold, he saw a cute little mold monster.
When Mold Takes Over Your Car
There is nothing worse than leaving your car for a few months when you travel and then returning to see that the state of it has not been maintained. This person left their car for a few months and then returned to this nightmare. Somehow there must have been a bit of moisture in the car and the mold had a great time overtaking the car. It would be hard to clean that out after.
Were they ever able to get the smell of the mold out of their car? It seems unlikely as the stench would linger for a long time.
Delicate Mold on Top of Water
If you never thought that the word delicate would be used to describe mold then you wouldn't be alone. That is not usually the first word that is used when you think of mold, but this mold is the exception. It is also unique as it grew on top of water. So not only is it very beautiful mold, but it is mold that is determined to grow no matter where.
It almost looks like a spider's web that has grown on top of the top. It's funny that it's actually mold.
Strawberries Covered in Snow or Mold?
It's hard to decide what is more comical in this photo...the fact that all of the strawberries are covered in mold that looks like snow or the fact that one of the strawberries is miraculously not moldy. How is it possible to be in such close proximity to something so "contagious" and not manage to get the mold on yourself...it seems a little bit suspicious to say the least.
The strawberries are so covered in mold that they almost look like they have created something that appears to be a baby duck or a chick when alas...it is just mold.
Even a Highlighter Can Get Moldy
You would be surprised how many things in life have the ability to get moldy. It was no doubt surprising to realize that water itself can get moldy, but did you know that highlighters can also get moldy? It may not be as obvious of a mold as some of the other items on this list, but if you look closely you will see it, fringing at the top of the marker.
It may not be a lot of mold, but a little can go a long way. It only takes a tiny amount to get the entire marker and other markers infested.
Wolf Brand Chili Grows Wolf Hair of Mold
Life lesson number 1: never leave your opened food in the fridge too long. This man made the mistake of opening a can of beans, not using all of the beans, covering it with aluminum foil, and then putting it back in the fridge. That could have all been harmless, except he forgot that the beans were in the back of the fridge and they very quickly started to morph into something else.
The wolf brand beans started to grow wolf like hairs of mold that overtook the entire can and started to even come out of the top of the can.
Minions Are Made From Moldy Peaches
Have you ever wondered how minions are created? Well the answer may be different than you were led to believe. In fact, if you were to go off of this picture alone, you may be led to believe that minions are created when mold overtakes a can of peaches that was left open and in the fridge for too long. After all, this picture could prove it to everyone.
The colors of this moldy can of canned peaches is actually pretty remarkable. Obviously, the peaches are a peachy orange color, but the water surrounding them also became a strange color of bright pink.
When You Ignore a Leaking Toilet for Years
It is tempting to just ignore some of life's problems, hoping that they will just go away. If you are one of the people who has the tendency to do that, then perhaps you should take a good look at this photo and change your life's course. This person had a leaking toilet for three years and decided to just ignore it and never tell their landlord about it. This is the end result.
It is almost impossible to fix a roof that is covered in that much mold. There is so much that you can pretty much never clean that up completely.
When the Moldy Spam Turns Into a Little Pet
This looks like it could almost be the little sidekick of one of the Disney princesses or one of the main characters of a Pixar film. There is something about this can of spam that turned into a fuzzy lump of mold that looks almost endearing, and even a little bit cute. However, it is probably far from endearing for the people who have to deal with cleaning up this moldy mess.
Instead of even attempting to clean this up, they should just throw it all away, including the plate that is underneath of it.
Wild Mold Growing From a Kiwi
This is perhaps the wildest version of mold that has been found of the list. Although some of the other moldy items were perhaps more intense or more covered, this mold is the wildest. Just look at the way it stands straight up and looks like a bunch of hairs that are reaching to the sky. All of that is coming out of a tiny piece of kiwi fruit.
Kiwis are pretty unique fruits on their own so it would make sense that they would have some unique mold growing out of them. You can't expect boring mold from a non boring fruit.
Grey Mold Mass on Top of Instant Coffee
Who doesn't love instant coffee? It is a great way to have coffee on the go and not have to worry about grinding beans or using an expensive machine to make a delicious cup of coffee. Although you might be led to believe that instant coffee does not have an expiration date...it does. Whether or not you believe the expiration date on the container or you believe this photo, know that you should be careful about how long you keep your instant coffee.
No one knows how long this coffee was kept in the cabinet before being discovered, covered in a blanket of thick grey mold.